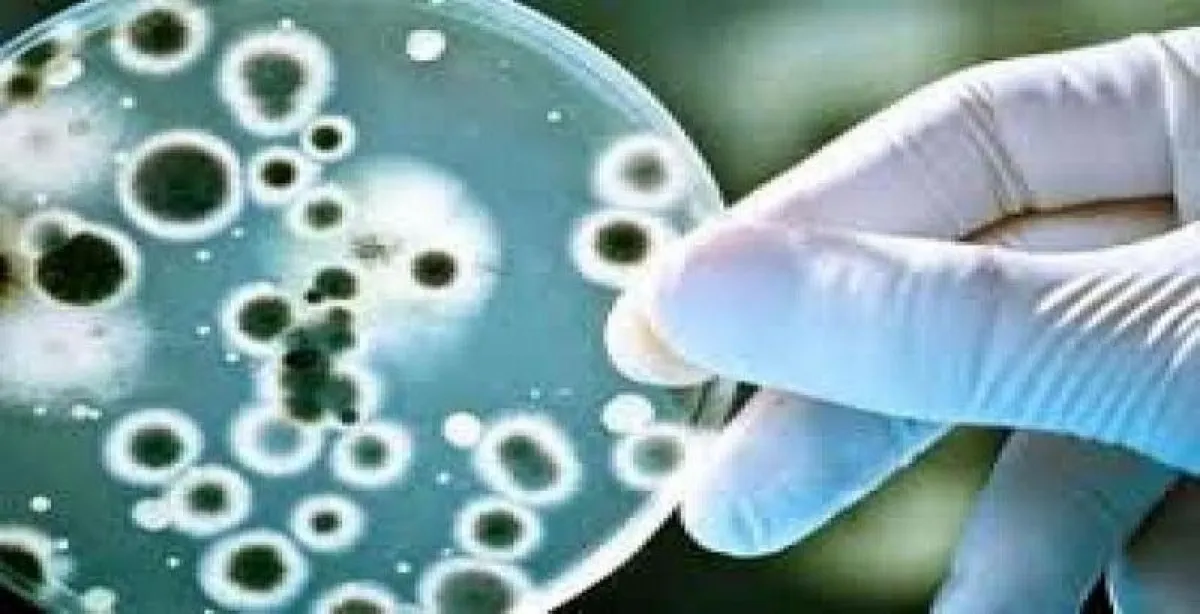

نشرت الهيئة العامة للغذاء والدواء مقطع فيديو مجهري يوضح عملية تأثير المضادات الحيوية على البكتيريا والقضاء عليها.
وأبانت الغذاء والدواء عبر حسابها الرسمي على موقع التواصل "تويتر"، أن المضادات الحيوية تستخدم للقضاء على البكتيريا وهى تعمل إما بالقضاء عليها مباشرة أو بإيقاف نموها أو إضعافها لكي يتغلب عليها الجهاز المناعي بالجسم، ومعظم الأمراض المعدية يتسبب فيها نوعان من الجراثيم هي، ""البكتيريا أو الفيروسات، والمضاد الحيوي يعالج العدوى البكتيرية لكنه لا يعالج العدوى الفيروسية مثل "الزكام والإنفلونزا وأغلب حالات احتقان الحلق".
وأوضحت الهيئة، أن استخدام المضاد الحيوي عشوائياً أو بجرعة أو مدة غير كافية يساهم في ظهور سلالات من البكتيريا لها القدرة على مقاومة العلاج، وكلما كثر استخدام المضاد الحيوي زادت فرصة الإصابة ببكتيريا مقاومة للمضادات الحيوية.
ونصحت الهيئة العامة للغذاء والدواء عند الإصابة بنزلة برد، بأخذ قسط من الراحة وتناول كثير من السوائل، وإذا كانت الأعراض مزعجة يطلب من الطبيب علاجاً للأعراض، وإذا زادت فترة المرض عن أسبوعين أو زادت حدة المرض، عندها يجب استشارة الطبيب.
إليكم الفيديو: